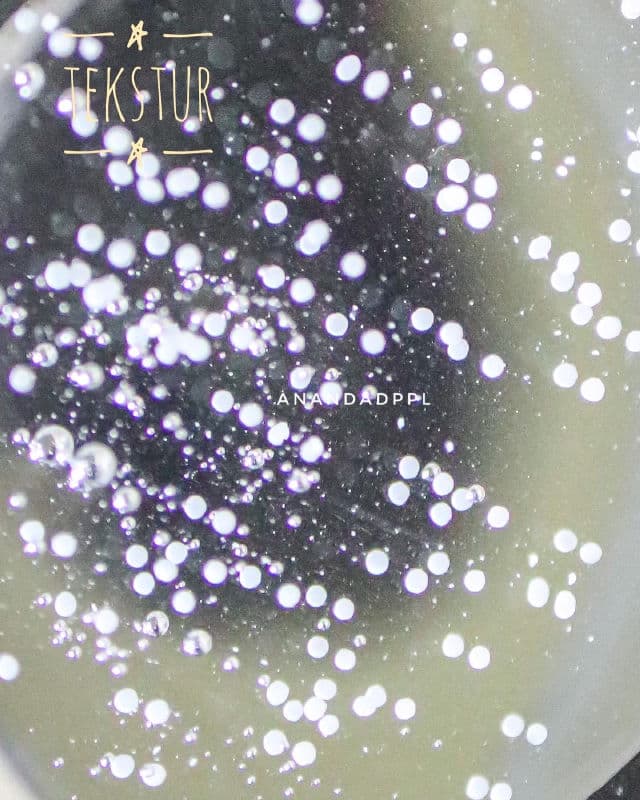
SKIN1004 Madagascar Centella Tone Brightening Capsule Ampoule review photo by anandadppl

𝗦𝗞𝗜𝗡𝟭𝟬𝟬𝟰 𝗠𝗮𝗱𝗮𝗴𝗮𝘀𝗰𝗮𝗿 𝗖𝗲𝗻𝘁𝗲𝗹𝗹𝗮 𝗧𝗼𝗻𝗲 𝗕𝗿𝗶𝗴𝗵𝘁𝗲𝗻𝗶𝗻𝗴 𝗖𝗮𝗽𝘀𝘂𝗹𝗲 𝗔𝗺𝗽𝗼𝘂𝗹𝗲 𝟭𝟬𝟬𝗺𝗹
Salah satu ampoule Wishlist aku dari @skin1004official kebetulan karena aku punya tonernya jadi hasilnya lebih nampol lagi.
𝗞𝗲𝗺𝗮𝘀𝗮𝗻
Untuk kemasannya sama seperti ampoule yang series sebelumnya ukurannya 100ml jadi lumayan gede, kemasan botol kacanya kokoh dengan aplikator pipet yang mudah digunakan
𝗧𝗲𝗸𝘀𝘁𝘂𝗿
Teksturnya lumayan kental mengandung butiran MadeWhite™, mampu menyerap dengan lembut ke dalam kulit dan merawat kulit menjadi kencang dan cerah tanpa terasa berminyak.
𝗞𝗲𝘆 𝗜𝗻𝗴𝗿𝗲𝗱𝗶𝗲𝗻𝘁𝘀
🍀 77% Centella Asiatica Extract : Menenangkan kulit sensitif dan memperkuat skin barrier
🍀 Niacinamide : Mencerahkan kulit
🍀 Betaine, Lactobacillus Ferment : Perawatan skin barrier
🍀 Xylity|glucoside, Anhydroxylitol, Xylitol : Menghidrasi
🍀 Madecassoside (MadeWhite™) : Mencerahkan dan membersihkan
𝗥𝗲𝘀𝘂𝗹𝘁
Karena aku punya line series ini tonernya dan hasil tonernya di aku bener-bener kerasa banget lembap dan brighteningnya jadi pas pake barengan di toner dan ampoule lebih kerasa banget cerah dan lembapnya. Selain itu karena ada kandungan Cica jadi pas kulitku berjerawat lumayan menenangkan juga, butiran madewhitenya lumer ketika dipalikasikan di wajah, walaupun teksturnya yang kental tapi menurutku diawal emang terasa lengket namun lambat kemudian rasa lengketnya hilang, aku pake ampoule ini hanya 1 drop untuk ngecover seluruh area wajah dan leher.
#pickyreview #gopicky #skin1004picky
@go.picky.id @pickyrewards @go.picky.id @skin1004_indonesia @skin1004_korea
#brighteningFocus #lighteningAmpoule #calming